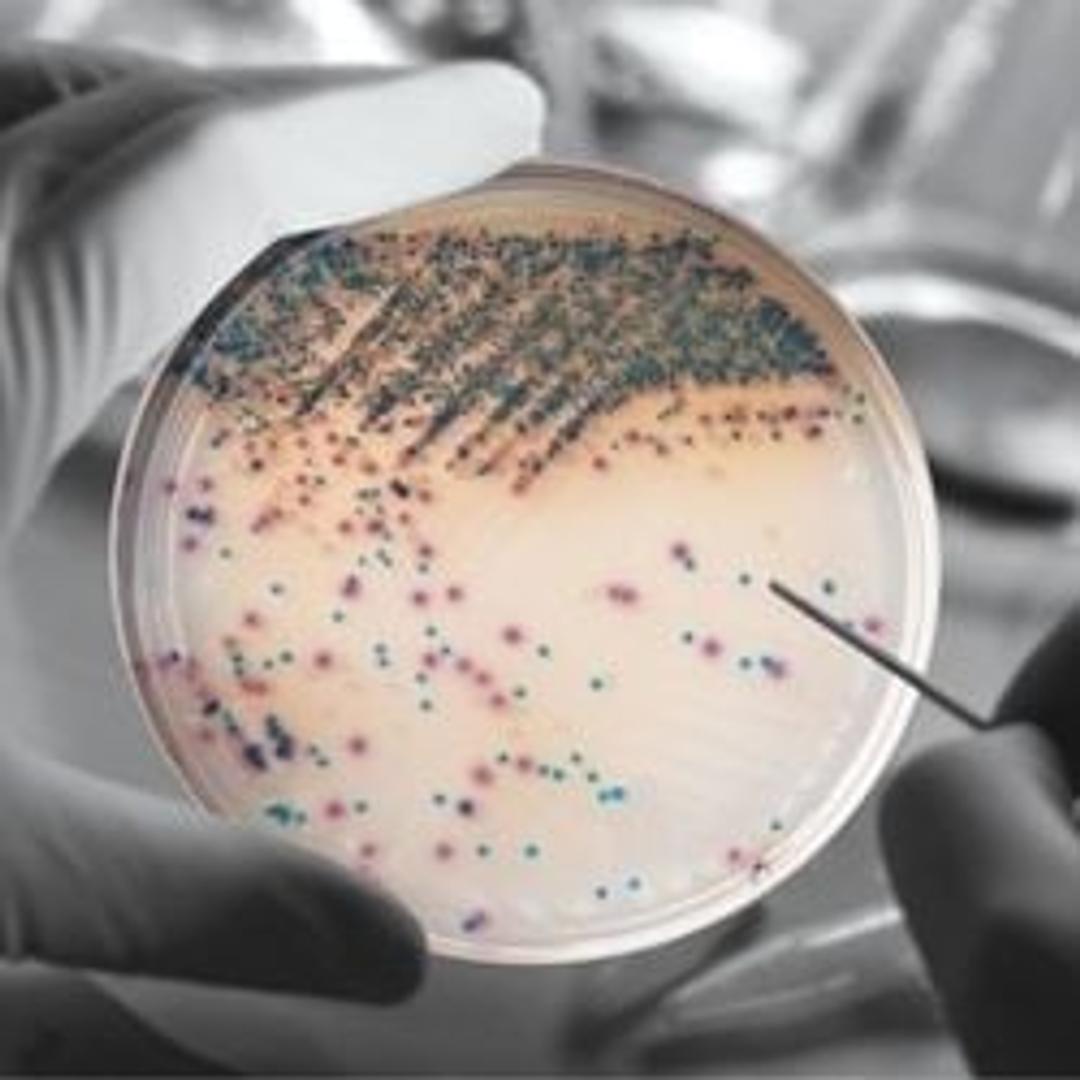
BD BBL™ CHROMagar™ Orientation Plate
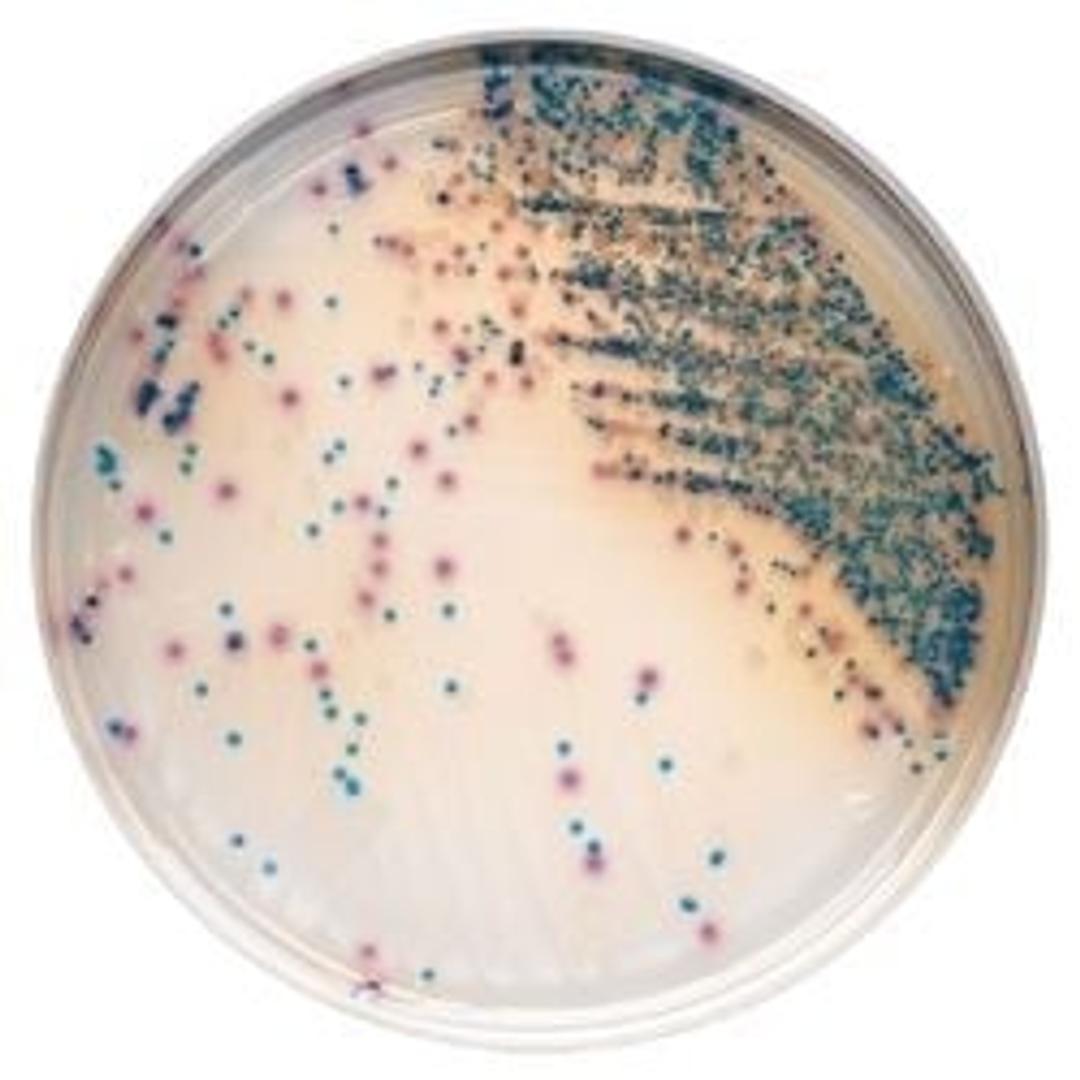
BD BBL™ CHROMagar™ Orientation Plate

BD BBL™ CHROMagar™ Orientation Plate
BD BBL™ CHROMagar™ Orientation medium is a non-selective, differential medium for presumptively identifying bacterial isolates from primary plating media. Specially selected peptones supply the nutrients in BD BBL™ CHROMagar Orientation medium. The chromogen mix consists of artificial substrates (chromogens) that release differently colored compounds upon degradation by specific microbial enzymes, thus assuring the direct dif…

The supplier does not provide quotations for this product through SelectScience. You can search for similar products in our Product Directory.
Great performance
Microbiology clinical
Excellent option for Urinary Tract Infection detection
Review Date: 6 Apr 2025 | BD Life Sciences
The BBL™ CHROMagar™ family of products utilize a chromogen mix that consists of artificial substrates (chromogens) that release differently colored compounds upon degradation by specific microbial enzymes, thus assuring the direct differentiation of certain species or the detection of certain groups of organisms with only a minimum of confirmatory tests.
BD BBL™ CHROMagar™ Orientation
A nonselective, differential medium for presumptively identifying bacterial isolates from primary clinical specimens. Specially selected peptones supply the nutrients in BBL CHROMagar Orientation medium.
• Direct identification of E. coli and Enterococci, and presumptive identification of Staphylococcus saprophyticus, Proteus mirabilis, and other UTI organisms.
• Enhances visual differentiation of colonies, resulting in less time spent sub-culturing mixed infections.
• Allows for earlier setup of susceptibility testing.
• Improves detection of mixed urine cultures for quicker assessment of contaminated samples,
decreasing work-up time.
• Immediately resolves approximately 80% of positive urines.
• Inhibits the swarming of Proteus spp. with a unique BBL formulation.
• The BD Kiestra™ Urine Culture Application detects growth and interprets samples grown on BD BBL™ CHROMagar™ Orientation to allow for an auto batch release.
Note: Not all products are available in all geographies, please contact your local BD representative for product details, specs, or ordering information.
Brochures
BD BBL CHROMagar
In this product brochure, BD Life Sciences provides an overview of its BD BBL™ CHROMagar range™. BBL CHROMagar products are designed to streamline identification, provide enhanced differentiation of pathogens and allow microbiologists to realize material and labor reductions in the laboratory. The BD BBL CHROMagar family uses a chromogen mix that releases colored compounds after degradation by specific microbial enzymes. You can visually detect the bacteria by a distinct color change within the colony, so you can easily differentiate species with minimal confirmatory tests. This application note is for the US only, for versions applicable to Europe, the Middle East, and Africa, click here.
BD BBL CHROMagar
Microbiology laboratories face multiple challenges when using diagnostic tools to effectively identify and differentiate bacteria in blood culture, stool, urine and HAI samples. If you work with standalone diagnostic solutions with no end-to end approach, you’re likely facing inefficient workflows that can compromise quality, increase your risk of errors, and reduce profitability. These errors and delays in identifying the cause of infections increases the risk of your clinicians making inappropriate antimicrobial choices. In this brochure, BD Life Sciences presents BD BBL™ CHROMagar™ family, and shows how it can optimize your workflow efficiency. The BD BBL CHROMagar family uses a chromogen mix that releases colored compounds after degradation by specific microbial enzymes. This application note is for Europe, Middle East, and Africa only, for the US version, click here